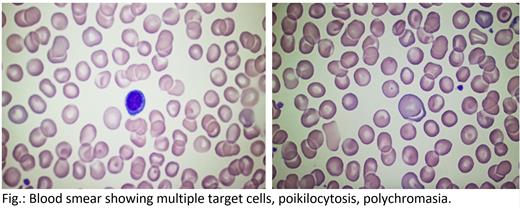
Figure 1

INTRODUCTION: Hematology has changed. Both benign and malignant hematology rely heavily on new diagnostic techniques, such as flow-cytometry, cytogenetics and most recently single gene analysis by next generation sequencing. Examination of a blood smear has come out of favor and is usually performed by lab technicians and not by the hematologist. This case report describes how examination of the blood smear which showed an unexpected red blood cell morphology eventually led after 40 years to the right diagnosis.
CASE: R. C. is a 42-year-old male (100 kg = 220 lbs, 1,83 m = 6 ft, BMI 29,9) diagnosed in childhood with spherocytosis. His medical history was remarkable for that after birth he needed blood exchange for kernicterus (bilirubin-induced brain dysfunction), and since age 3 months he had epileptic seizures. His blood counts were not that abnormal and since he had no or only mild anemia throughout his whole life he received no further w/u for his blood disorder. Another remarkable finding was that he always had hyperkalemia but since he had no symptoms (no palpitations, dyspnea, chest pain, nausea, or vomiting) and nobody found an explanation no further workup was pursued. In November 2022 he presented to a nearby hospital for epileptic seizures. His spleen was mildly enlarged (14,5 x 6,7 cm) and because of his h/o spherocytosis the neurologist sent him for hematologic re-evaluation.
His physical was unremarkable except for that the margin of the spleen was palpable. He was neither pale nor icteric. He drinks no alcohol and does not smoke. Medications were lamotrigen, cholecalciferol, and cenobamate.
His blood counts are shown in the table. Since his MCHC was normal, which does not fit spherocytosis, we ordered a blood smear shown in the figure. There were no spherocytes but many target cells. Then we sent for an eosin-5′-maleimide (EMA) binding test which was also unremarkable (124% binding, with spherocytosis usually < 80%). However, acidified glycerol lysis test showed increased osmotic fragility (lysis time 45 sec., normal > 1800 sec). This unusual combination together with his hyperkalemia led to the hypothesis of a disorder related to the xerocytosis or stomatocytosis complex. However, the morphologic picture did not fit stomatocytosis. We therefore sent for NGS analysis which revealed a heterozygous mutation of SLC2A1, variant c.857G>A; p.Gly286Asp (stomatin-deficient cryohydrocytosis). Stomatin-deficient cryohydrocytosis is a very rare congenital deficiency in GLUT1 and stomatin with moderate hemolytic anemia, pseudohyperkalemia and various neurologic defects. The occurrence of target cells (but no stomatocytes) with cryohydrocytosis has - to our knowledge - been reported only once before.
CONCLUSIONS: In Germany benign hematology no longer plays the role it had 30-40 years ago. This may be due to the fact that congenital anemias and erythrocyte abnormalities occur less frequently in the relatively homogeneous German population, at least less often than in southeastern Europe or in other countries. Also, patients with mild stable anemia that do not require treatment, are often not seen by a hematologist. To the authors' opinion the most relevant change is that blood smear examination, which is reimbursed with 50 cents has fallen out of fashion in daily practice.
However, in this case only the blood smear revealed, that the prior diagnosis of spherocytosis could not be correct. There were no spherocytes but target cells. The patient, though, had not the typical factors associated with target cells (no liver disease, no hyperlipidemia, no thalassemia or iron deficiency). Eventually NGS analysis revealed stomatin-deficient cryohydrocytosis.
We present this case because it was the blood smear examination that eventually led to the right diagnosis. All hematologists should have a microscope “next door” and even if blood smear examination is reimbursed poorly it is a diagnostic tool still at the core of our profession
Disclosures
No relevant conflicts of interest to declare.

This feature is available to Subscribers Only
Sign In or Create an Account Close Modal